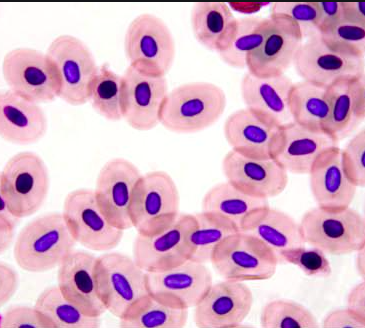

Are these plant or animal cells? How do you know?

Is this a prokaryote or a eukaryote? How do you know?

An example of an organism with prokaryotic cells is a(n)...
This organelle is found in plant cells but not animal cells.
Which of the following organelles can be found in animal cells:
If a cell contains a nucleus, it must be a(n) ____.
Which of the following is a function of the nucleus
Which organelle would you expect to find in plant cells but not animal cells?
Which of the following conclusions could you draw about the model?

The primary function of the cell wall is to
You will NOT find a cell wall in which of these kinds of organisms? Select all that apply.
Which of the following is a function of the cell membrane?
Match the organelle to its function.
| Stavka koja se može prevući | arrow_right_alt | Odgovarajuća stavka |
|---|---|---|
The liquid in the cell where the other organelles float | arrow_right_alt | Nucleus |
Uses the sun's energy to make food | arrow_right_alt | Mitochondria |
Contains the DNA and controls the cell | arrow_right_alt | Cell Membrane |
Make the energy for the cell to do work | arrow_right_alt | Cell Wall |
Provides structure and strength the the cell | arrow_right_alt | Cytoplasm |
Determines what can enter or leave the cell | arrow_right_alt | Chloroplast |
Place all the choices into the correct cell category.
Cell Membrane
Round/Blob-like

Square/Box-like
Chloroplast
Cytoplasm
Mitochondria
Cell Wall
Nucleus
ONLY Plant Cells
ONLY Animal Cells
BOTH Plant and Animal Cells